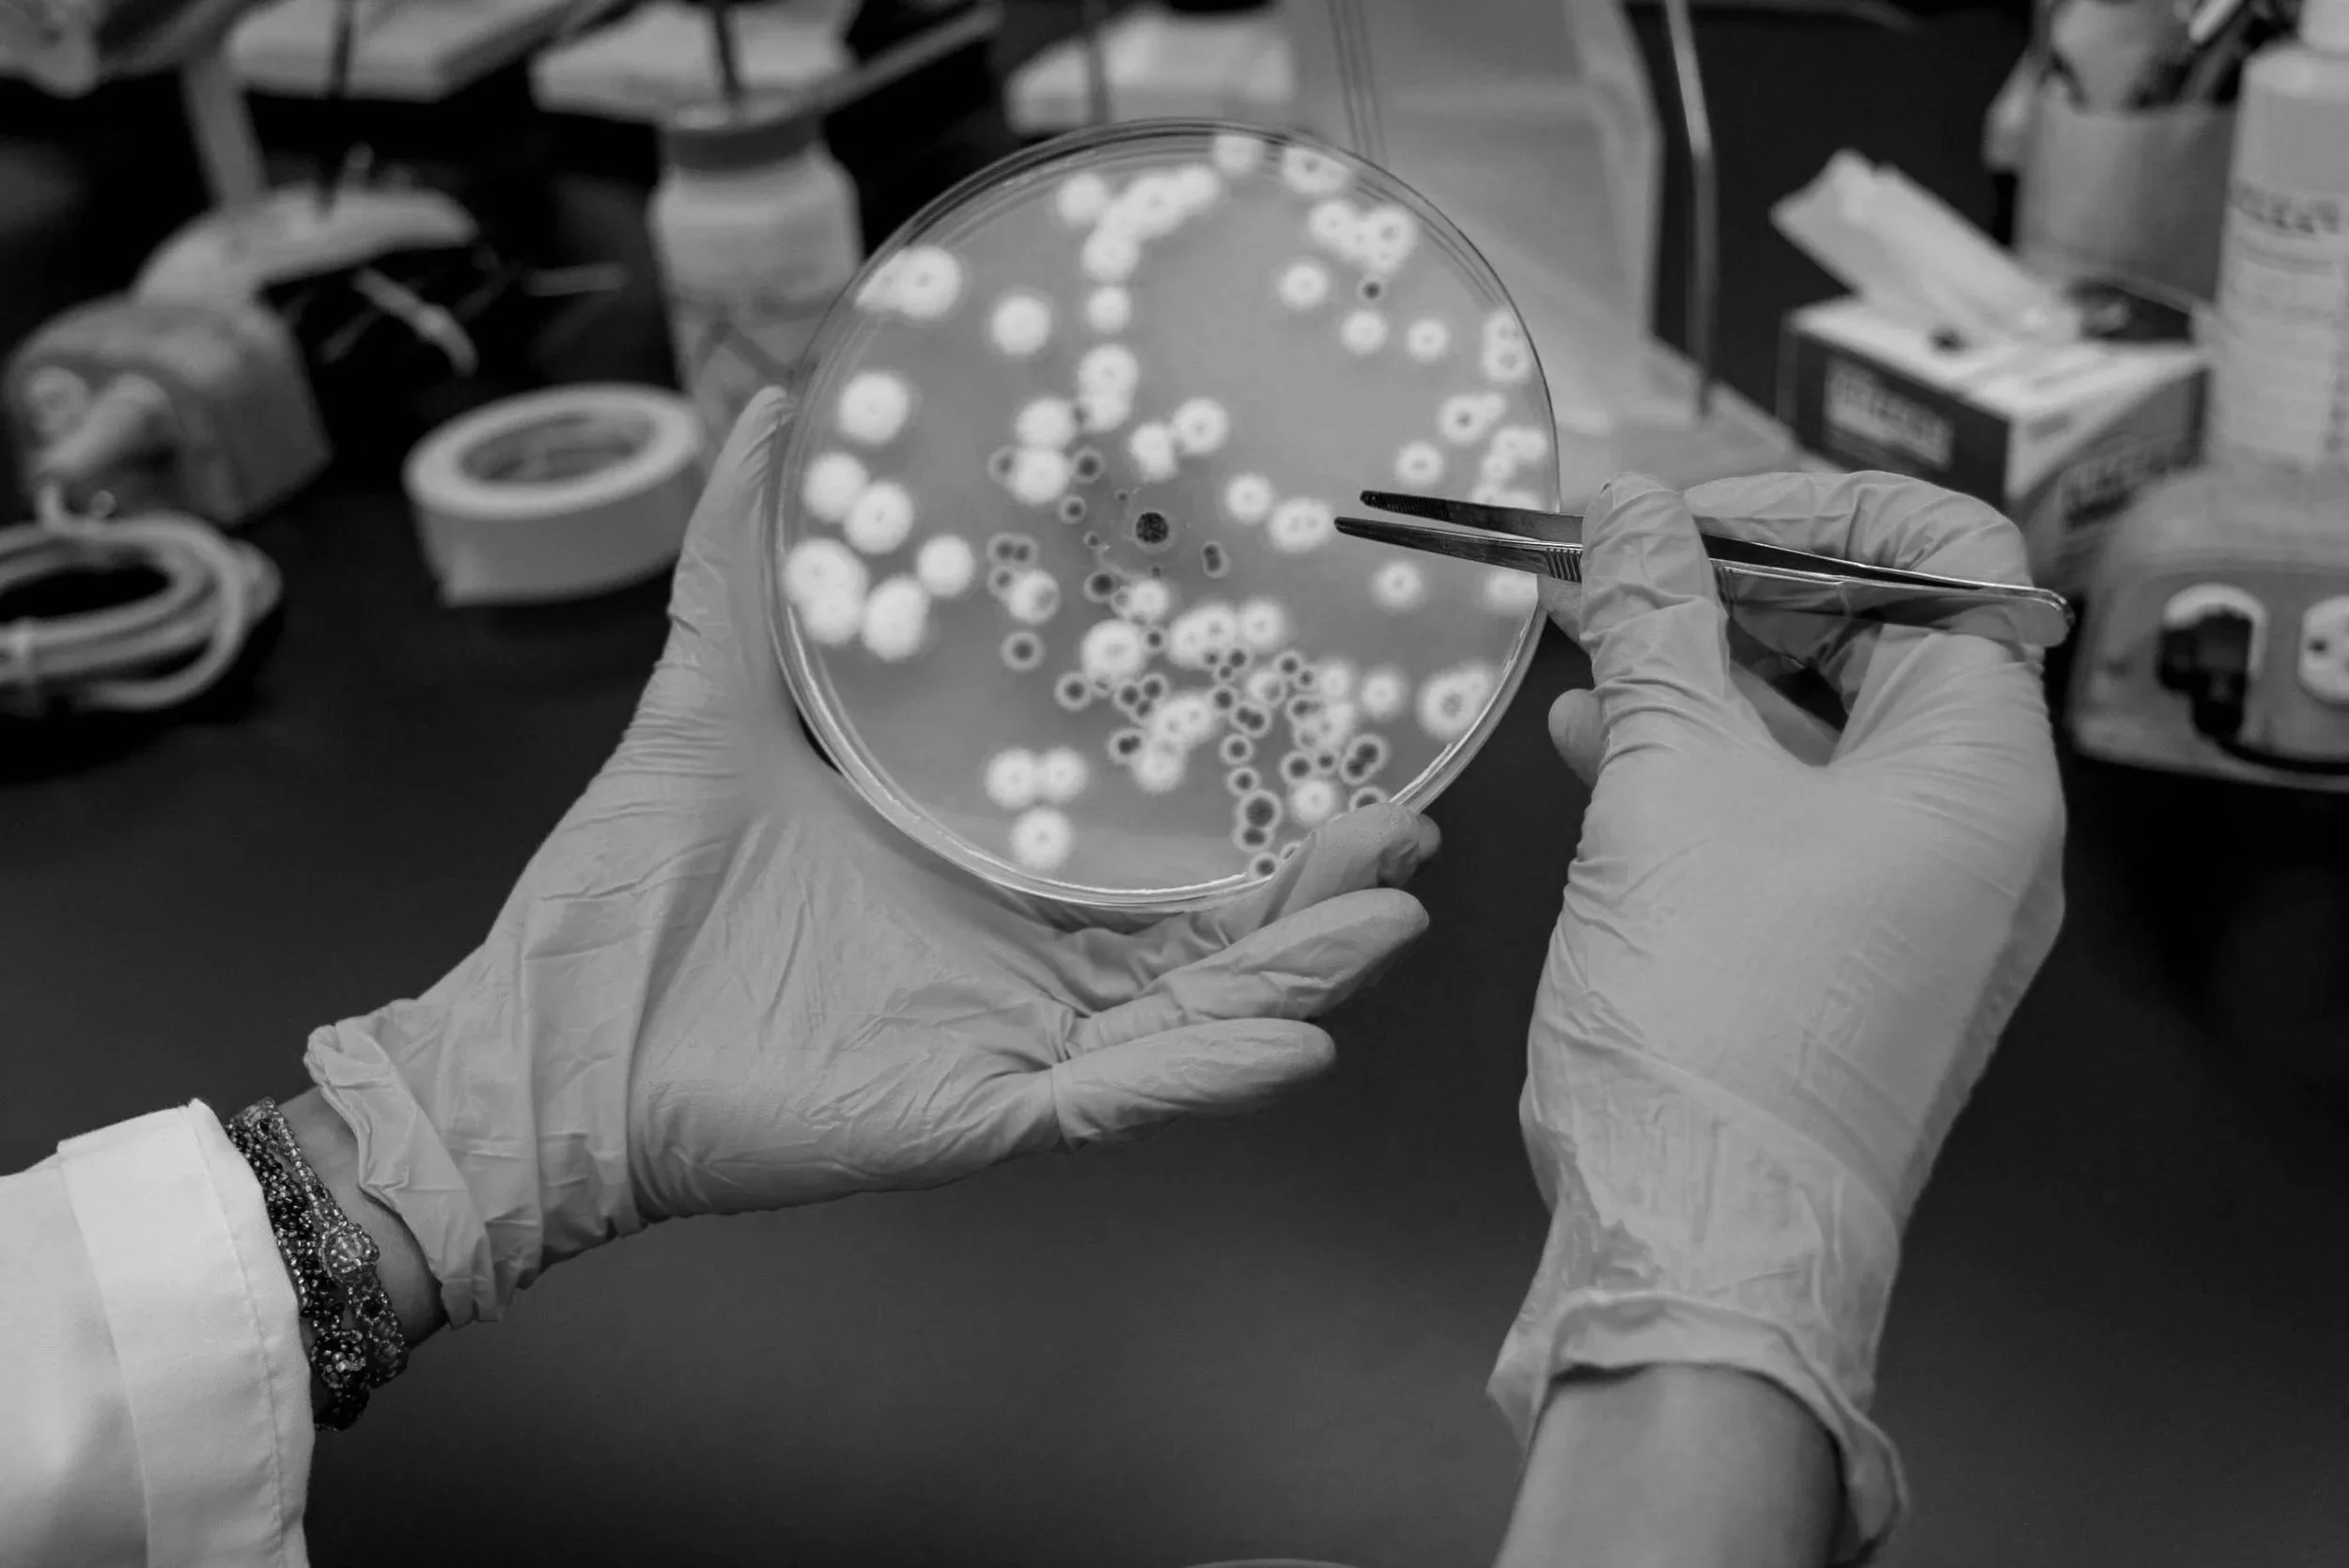
El análisis del microbioma intestinal revela desequilibrios bacterianos —o disbiosis— vinculados a procesos de inflamación que podrían influir en el desarrollo del alzhéimer.

El intestino como brújula del cerebro: cómo la microbiota y la dieta influyen en el riesgo de sufrir alzhéimer
El alzhéimer podría empezar mucho antes de los primeros olvidos… y no en el cerebro, sino en el intestino. Un estudio con inteligencia artificial demuestra cómo la dieta y la microbiota pueden anticipar —y quizá prevenir— el riesgo de padecer este tipo de demencia.
Por Enrique Coperías, periodista científico
El deterioro cognitivo asociado al alzhéimer tiene un fuerte impacto en la vida diaria, pero nuevas investigaciones apuntan a que su origen podría estar también en factores como la dieta y la salud intestinal. Image by Gerd Altmann from Pixabay
La investigación del alzhéimer se ha centrado casi de menera exclusiva en el cerebro. Allí se han buscado desde hace décadas las huellas de la enfermedad: placas de beta-amiloide, ovillos de proteína tau, señales de inflamación neuronal… Sin embargo, en los últimos años, un nuevo protagonista ha irrumpido con fuerza en este campo: el intestino. Y con él, una hipótesis que gana cada vez más peso: lo que ocurre en nuestra microbiota intestinal podría influir, incluso de forma decisiva, en el riesgo de desarrollar una demencia.
Un reciente estudio publicado en la revista Alzheimer’s & Dementia: Diagnosis, Assessment & Disease Monitoring refuerza esta idea y aporta un giro de guion relevante: no solo sugiere que el eje intestino-cerebro desempeña un papel en la enfermedad, sino que abre la puerta a estrategias de prevención del alzhéimer basadas en factores modificables, como la dieta y la salud metabólica.
La investigación, liderada por Tallat Jabeen y su equipo de la Universidad Tecnológica de Sídney (Australia), combina la inteligencia artificial (IA) con análisis del microbioma intestinal en casi 10.000 personas. El objetivo: identificar señales precoces del riesgo de padecer alzhéimer utilizando datos accesibles, como son los hábitos alimentarios, el historial médico y el estilo de vida, en lugar de pruebas invasivas o costosas.
¿Qué relación hay entre el intestino y el alzhéimer?
El alzhéimer es una enfermedad neurodegenerativa que afecta ya a más de 55 millones de personas en el mundo; esta cifra podrísa triplicarse en las próximas décadas. Sin embargo, detectarlo a tiempo sigue siendo un desafío. Las técnicas más precisas, como el análisis del líquido cefalorraquídeo y las pruebas de neuroimagen, son caras, invasivas y, en muchos casos, llegan demasiado tarde, cuando el daño neuronal es irreversible.
De ahí el interés por imdagar en métodos alternativos que permitan anticipar el riesgo antes de que aparezcan los síntomas. En ese contexto, el intestino emerge como una pieza clave. Alberga más de 100 billones de microorganismos que no solo participan en la digestión, sino que también producen compuestos capaces de influir en el sistema nervioso.
Estos microbios generan, por ejemplo, ácidos grasos de cadena corta —moléculas con efectos antiinflamatorios— y precursores de neurotransmisores. También regulan la permeabilidad intestinal: cuando este equilibrio se rompe, sustancias proinflamatorias pueden pasar al torrente sanguíneo y afectar al cerebro.
Diversos estudios habían observado ya que las personas con alzhéimer presentan una microbiota alterada: menor diversidad bacteriana y un desequilibrio entre especies beneficiosas y perjudiciales. Pero quedaba en el aire una pregunta fundamental por responder: ¿hasta qué punto esa alteración es causa, consecuencia o simple reflejo de otros factores como la dieta o las enfermedades crónicas?
Un modelo predictivo basado en la vida cotidiana
El trabajo de Jabeen intenta responder a esa cuestión integrando múltiples variables en un único modelo. Para ello, ella y sus colegas Faezeh Karimi, Ali R. Zomorrodi y Kaveh Khalilpour analizaron datos de 9.832 participantes, que incluían más de 120 características agrupadas en cinco categorías: demografía, dieta, nutrición, estilo de vida e historial médico.
A partir de estos datos, los cuatro investigadores entrenaron varios algoritmos de aprendizaje automático capaces de distinguir entre personas con y sin alzhéimer. Los resultados de este trabajo son llamativos: los modelos lograron una precisión elevada utilizando solo información obtenida mediante cuestionarios.
Pero más interesante aún es qué variables resultaron más predictivas. Contra lo que cabría esperar, los factores más potentes no fueron los genéticos ni los puramente demográficos, sino dos categorías claramente modificables:
✅ El historial médico.
✅ Los patrones dietéticos.
Un hallazgo inesperado: el papel del apéndice
En este punto, uno de los hallazgos más sorprendentes de esta investigación introduce una pieza inesperada en el puzle.
🗣️ «El resultado más inesperado del estudio fue quizá también uno de los más reveladores: las personas a las que se les había extirpado el apéndice —una de las intervenciones quirúrgicas más rutinarias del mundo— mostraban un riesgo significativamente mayor de alzhéimer, convirtiéndose en uno de los factores más influyentes de todo el análisis —explica Khalilpour. Y añade—: Especulamos que el apéndice actúa como un reservorio de bacterias intestinales beneficiosas. Cuando se extirpa, el microbioma pierde un mecanismo clave de recuperación: su capacidad de restablecer comunidades microbianas saludables tras enfermedades, infecciones o el uso de antibióticos».
En palabras de este experto en ingeniería de sistemas, «a lo largo de las décadas, esta alteración podría acumularse, dejando al intestino progresivamente menos capaz de proteger al cerebro frente a las señales inflamatorias vinculadas a la neurodegeneración».
Por otro lado, os antecedentes de enfermedades cardiovasculares, diabetes, depresión o hipertensión destacaron como indicadores muy relevantes. No es una sorpresa total: desde hace años se sabe que la salud vascular está estrechamente relacionada con la neurodegeneración. Pero el estudio refuerza la idea de que el alzhéimer no es solo una enfermedad del cerebro, sino también del sistema metabólico.
Los patrones dietéticos ricos en fibra, vegetales y omega-3 favorecen una microbiota saludable y se asocian con un menor riesgo de alzhéimer, según el estudio. Foto de Nathan Dumlao en Unsplash
Dieta y patrones alimentarios
En paralelo, la dieta mostró un poder predictivo similar. Los patrones alimentarios —más que los nutrientes aislados— fueron determinantes.
«Más que los nutrientes individuales, el estudio encontró que los patrones globales de alimentación eran más informativos —señala Khalilpour. Y añade—: Las dietas ricas en proteína vegetal, lácteos, ácidos grasos omega-3 y alimentos integrales se asociaron de forma consistente con un menor riesgo de alzhéimer, mientras que las dietas dominadas por alimentos procesados, azúcares refinados y grasas saturadas apuntaban claramente en la dirección opuesta».
Dietas ricas en fibra, omega-3 y alimentos de origen vegetal se asociaron con menor riesgo, mientras que el consumo elevado de ultraprocesados, azúcares y grasas saturadas apuntaba en la dirección contraria.
«Cabe destacar que los patrones dietéticos generales superaron a las mediciones de nutrientes individuales —dice Khalilpour—. Es decir, no es una vitamina o suplemento concreto lo que importa, sino el efecto acumulado y cotidiano de cómo come una persona a lo largo de los años y las décadas».
Microbiota intestinal y disbiosis
Pero ¿dónde encaja el intestino en todo esto? El estudio ofrece una pista: los mismos factores que predicen el riesgo de alzhéimer —dieta y salud metabólica— son también los que moldean la microbiota.
En un subgrupo de 2.000 participantes, Jabeen y su equipo analizaron directamente la composición bacteriana del intestino. Los resultados muestran un patrón de disbiosis, es decir, un desequilibrio microbiano caracterizado por menor diversidad y pérdida de bacterias beneficiosas.
🗣️ «Las bacterias beneficiosas responsables de producir ácidos grasos de cadena corta —compuestos que mantienen la barrera protectora del intestino y suprimen activamente la neuroinflamación— estaban significativamente reducidas — explica Karimi. Y añade—: La diversidad microbiana era menor. En su lugar, se había establecido un entorno microbiano más inflamatorio, que parece capaz de enviar señales dañinas a través del eje intestino-cerebro directamente al cerebro».
En particular, se observó una reducción de microorganismos productores de ácidos grasos de cadena corta, como las bacterias de los géneros Roseburia y Faecalibacterium, esenciales para mantener la integridad de la barrera intestinal y modular la inflamación. Al mismo tiempo, aumentaban especies asociadas a procesos inflamatorios.
Uno de los indicadores más reveladores fue la relación entre los géneros Prevotella y Bacteroides, que alcanzaba valores elevados en personas con mayor riesgo. Este tipo de métricas sugiere cambios en la forma en que el microbioma procesa los nutrientes y produce metabolitos.
En conjunto, estos datos apuntan a un mecanismo plausible: una dieta poco saludable altera la microbiota; esta, a su vez, favorece la inflamación sistémica y la disfunción metabólica; y ambos procesos contribuyen al deterioro cognitivo.
«La implicación es significativa: si la dieta contribuye a la neurodegeneración, también puede, potencialmente, ayudar a prevenirla», resume Zomorrodi.
El análisis del microbioma intestinal revela desequilibrios bacterianos —o disbiosis— vinculados a procesos de inflamación que podrían influir en el desarrollo del alzhéimer. Foto de Trust "Tru" Katsande en Unsplash
Señales sorprendentes y cautelas necesarias
Como ocurre en muchos estudios basados en grandes bases de datos, algunos resultados pueden parecer inesperados. Por ejemplo, ciertas variables como el consumo de lactosa o el uso de antibióticos mostraron asociaciones difíciles de interpretar de forma directa.
Los propios autores advierten de que estos hallazgos deben tomarse con cautela. El estudio es observacional y transversal, lo que significa que no permite establecer relaciones causales. Es decir, no se puede afirmar que una determinada bacteria o hábito cause alzhéimer, solo que está asociado a él.
Además, aunque el modelo predictivo es potente, no sustituye a los métodos diagnósticos clínicos. Su valor reside más bien en el cribado precoz: identificar a personas con mayor riesgo para aplicar medidas preventivas antes de que aparezcan los síntomas.
Una ventana a la prevención el alzhéimer
A pesar de estas limitaciones, el trabajo tiene, sin duda alguna, implicaciones importantes:
1️⃣ Demuestra que es posible estimar el riesgo de alzhéimer con herramientas accesibles y de bajo coste, basadas en información cotidiana.
2️⃣ Refuerza la idea de que existen factores modificables capaces de influir en ese riesgo.
Y aquí es donde el intestino adquiere un papel protagonista. Si la microbiota actúa como intermediaria entre la dieta, el metabolismo y el cerebro, entonces intervenir sobre ella podría convertirse en una estrategia preventiva.
No se trata de una idea completamente nueva. Dietas como la mediterránea, la DASH (Enfoques Alimentarios para Detener la Hipertensión) y la MIND (Intervención Mediterránea-DASH para el Retraso Neurodegenerativo) ya han mostrado efectos protectores frente al deterioro cognitivo. Lo que aporta este estudio es un posible mecanismo biológico que conecta esos patrones alimentarios con la salud cerebral.
En otras palabras, cuidar lo que comemos no solo alimenta al cuerpo: también puede estar moldeando, a través de los microbios intestinales, la forma en que envejece nuestro cerebro.
🗣️ «Este hallazgo es especialmente convincente, ya que indica que la salud cerebral a largo plazo puede estar moldeada por experiencias tempranas de la vida a través de sus efectos duraderos sobre el microbioma intestinal —apunta Jabeen. Y puntualiza—: Replantea cómo pensamos el riesgo de alzhéimer: no como algo que aparece en la vejez, sino como un proceso que se va acumulando silenciosamente a lo largo de toda la vida».
De la correlación a la causalidad
El siguiente paso será confirmar estas asociaciones en estudios longitudinales, que sigan a las personas a lo largo del tiempo para ver cómo evolucionan su microbiota y su función cognitiva. También será clave explorar intervenciones concretas: cambios en la dieta, probióticos, prebióticos o incluso trasplantes fecales.
La inteligencia artificial, por su parte, seguirá desempeñando un papel central. Su capacidad para integrar grandes volúmenes de datos —genéticos, clínicos, ambientales— permite captar patrones complejos que escapan al análisis tradicional.
Pero quizá la lección más relevante de este trabajo es conceptual. Durante años, el alzhéimer se ha abordado como una enfermedad localizada en el cerebro. Hoy, cada vez más investigaciones apuntan a una visión sistémica, en la que el intestino, el metabolismo y el sistema inmunitario forman parte del mismo entramado.
En ese escenario, la prevención del alzhéimer podría empezar mucho antes de lo que se pensaba: no en el laboratorio ni en el hospital, sino en la mesa, en el estilo de vida y, en última instancia, en ese ecosistema invisible que llevamos dentro.
«Identificar a las personas con riesgo elevado de forma temprana, antes de que aparezca cualquier síntoma cognitivo, crea una ventana de oportunidad para actuar: cambios en la dieta, terapias dirigidas al microbioma y un mejor control cardiovascular. Esa ventana se reduce drásticamente una vez que el alzhéimer ya se ha manifestado», advierte Karimi. Y concluye—: La validación mediante estudios a largo plazo es el siguiente paso esencial. Pero la dirección de la evidencia es clara: el alzhéimer puede no comenzar en el cerebro. Puede empezar de forma silenciosa, años antes, en el intestino, moldeado por lo que comemos, las bacterias que albergamos y nuestra historia médica a lo largo de la vida».▪️(21-abril-2026)
PREGUNTAS&RESPUESTAS: Microbiota y Alzhéimer
🧠 ¿Puede la microbiota causar alzhéimer?
No se ha demostrado causalidad directa, pero existe una fuerte asociación entre disbiosis intestinal y riesgo de alzhéimer.
🧠 ¿Qué dieta ayuda a prevenir el alzhéimer?
Dietas ricas en:
Vegetales
Fibra
Omega-3
Alimentos integrales
Estos ingredietes son comunes en la dieta mediterránea, que se asocia con un menor riesgo de sufrir demencia.
🧠 ¿Qué es el eje intestino-cerebro?
Es la comunicación bidireccional entre el intestino y el cerebro, mediada por el sistema nervioso, inmunitario y metabólico.
🧠 ¿Se puede detectar el riesgo de alzhéimer sin pruebas invasivas?
Sí. Este estudio muestra que cuestionarios sobre dieta y salud combinados con IA pueden predecir el riesgo con alta precisión.
SALUD Y NUTRICIÓN FEMENINA
Información facilitada por la Universidad Tecnológica de Sídney
Fuente: Tallat Jabeen, Faezeh Karimi, Ali R. Zomorrodi, Kaveh Khalilpour. Multi-modal machine learning and gut microbiome pathway analysis for Alzheimer's risk prediction. Alzheimer s & Dementia Diagnosis Assessment & Disease Monitoring (2026). DOI: https://doi.org/10.1002/dad2.70340